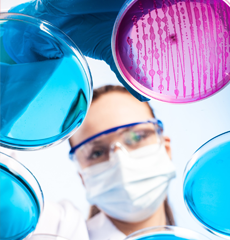

CHOOSE US
Protect your property by choosing the regional experts in indoor air quality. We'll catch any dangers and eliminate them for you!

QUALIFIED TO HELP
We're a member of the Indoor Air Quality Association and other relevant trade groups.

IT'S ABOUT YOUR HEALTH
Your home or business' air quality isn't about odors - it's about healthy, breathable air.
WHAT DO YOU NEED?
We specialize in inspections, remediation, and prevention of airborne pathogens.


